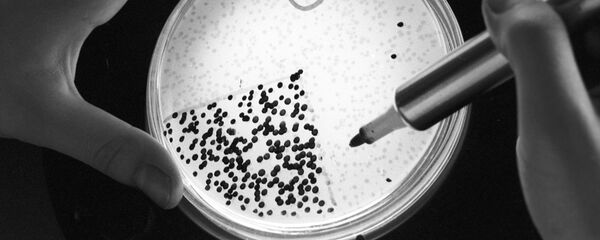
Vi khuẩn  - Sputnik Việt Nam

Tin đồn thất thiệt về “vi khuẩn ăn thịt người”
Ngày 16/9, trên trang Facebook cá nhân Hoàng Thanh Huyền (23 tuổi, trú TP Đồng Hới) đăng tải nội dung: “Bệnh viện hữu nghị Việt Nam Cuba - Đồng Hới có 3 ca nhiễm vi khuẩn ăn thịt người”. Thông tin sai sự thật này sau đó được nhiều người dùng Facebook chia sẻ, bình luận khiến người dân trên địa bàn tỉnh Quảng Bình hoang mang, lo lắng.
Trước tình hình đó, Sở Y tế tỉnh Quảng Bình tiến hành xác minh và khẳng định tại địa phương này không có trường hợp nào bị nhiễm “vi khuẩn ăn thịt người” (Whitmore) như mạng xã hội lan truyền. Đó chỉ là tin đồn thất thiệt, gây ảnh hưởng rất lớn trong quá trình khám chữa bệnh cho người dân tại Bệnh viện hữu nghị Việt Nam – Cuba Đồng Hới nói riêng, và các bệnh viện trên địa bàn tỉnh nói chung.
Công an Quảng Bình nhanh chóng truy xét và triệu tập Hoàng Thanh Huyền đến làm việc. Huyền sau đó chia sẻ do nghe mọi người kể, nên đăng thông tin lên trang Facebook của mình để cảnh giác. Sau khi làm việc với cơ quan chức năng Huyền nhận ra thông tin đó chưa đúng, chưa kiểm chứng và đã nhận ra lỗi của mình.
Hành vi của Hoàng Thanh Huyền đã vi phạm Điểm e, Khoản 1, Nghị định số 72/2013/NĐ-CP, ngày 15/7/2013 của Chính phủ về Quản lý, cung cấp dịch vụ Internet và thông tin trên mạng.
Với hành vi vi phạm này, Hoàng Thanh Huyền đã bị Công an tỉnh Quảng Bình xử phạt vi phạm hành chính với số tiền 12,5 triệu đồng hôm 01/10.
“Vi khuẩn ăn thịt người” là vi khuẩn gì?
Bệnh “vi khuẩn ăn thịt người” (còn gọi là Whitmore hoặc Melioidosis) là bệnh truyền nhiễm cấp tính nguy hiểm do vi khuẩn Burkholderia pseudomallei sống trong môi trường tự nhiên gây ra.
Whitmore có biểu hiện lâm sàng rất đa dạng, tiến triển nhanh với tỷ lệ tử vong cao nếu bệnh nhân không được chẩn đoán đúng và điều trị kháng sinh phù hợp.
Bất kỳ ai đều có thể bị nhiễm Whitmore thông qua tiếp xúc trực tiếp với đất và nước mặt bị ô nhiễm. Con người và động vật được cho là bị nhiễm trùng do hít phải bụi bẩn hoặc giọt nước bị nhiễm bẩn, uống phải nguồn nước bị ô nhiễm và tiếp xúc với đất bị ô nhiễm, đặc biệt là qua các vết trầy xước trên da.
Rất hiếm khi người bệnh bị mắc bệnh do lây truyền từ người khác. Một vài trường hợp đã được ghi nhận đều bắt nguồn từ việc đất và nước mặt bị ô nhiễm.
“Bệnh cảnh lâm sàng của bệnh Whitmore đa dạng phức tạp như sốt với các kiểu như sốt cơn hoặc sốt kèm theo lạnh run, sốt kéo dài, suy hô hấp, loét da, viêm đường tiết niệu, viêm phổi, áp xe ở gan, lách, nhiễm trùng huyết, suy đa phủ tạng. Bệnh nhân có nguy cơ bị chẩn đoán nhầm với bệnh khác như: bệnh viêm phổi, bệnh lao phổi, áp xe cơ, bệnh nhiễm trùng huyết do các vi khuẩn khác như tụ cầu, liên cầu...”, bác sĩ Chuyên khoa II Phạm Ngọc Hàm, Trưởng khoa Y học nhiệt đới, Bệnh viện Đà Nẵng cho hay.
Hiện nay, Whitmore là căn bệnh chưa có thuốc tiêm phòng, cũng chưa có bất kỳ khuyến cáo nào về sử dụng kháng sinh dự phòng.